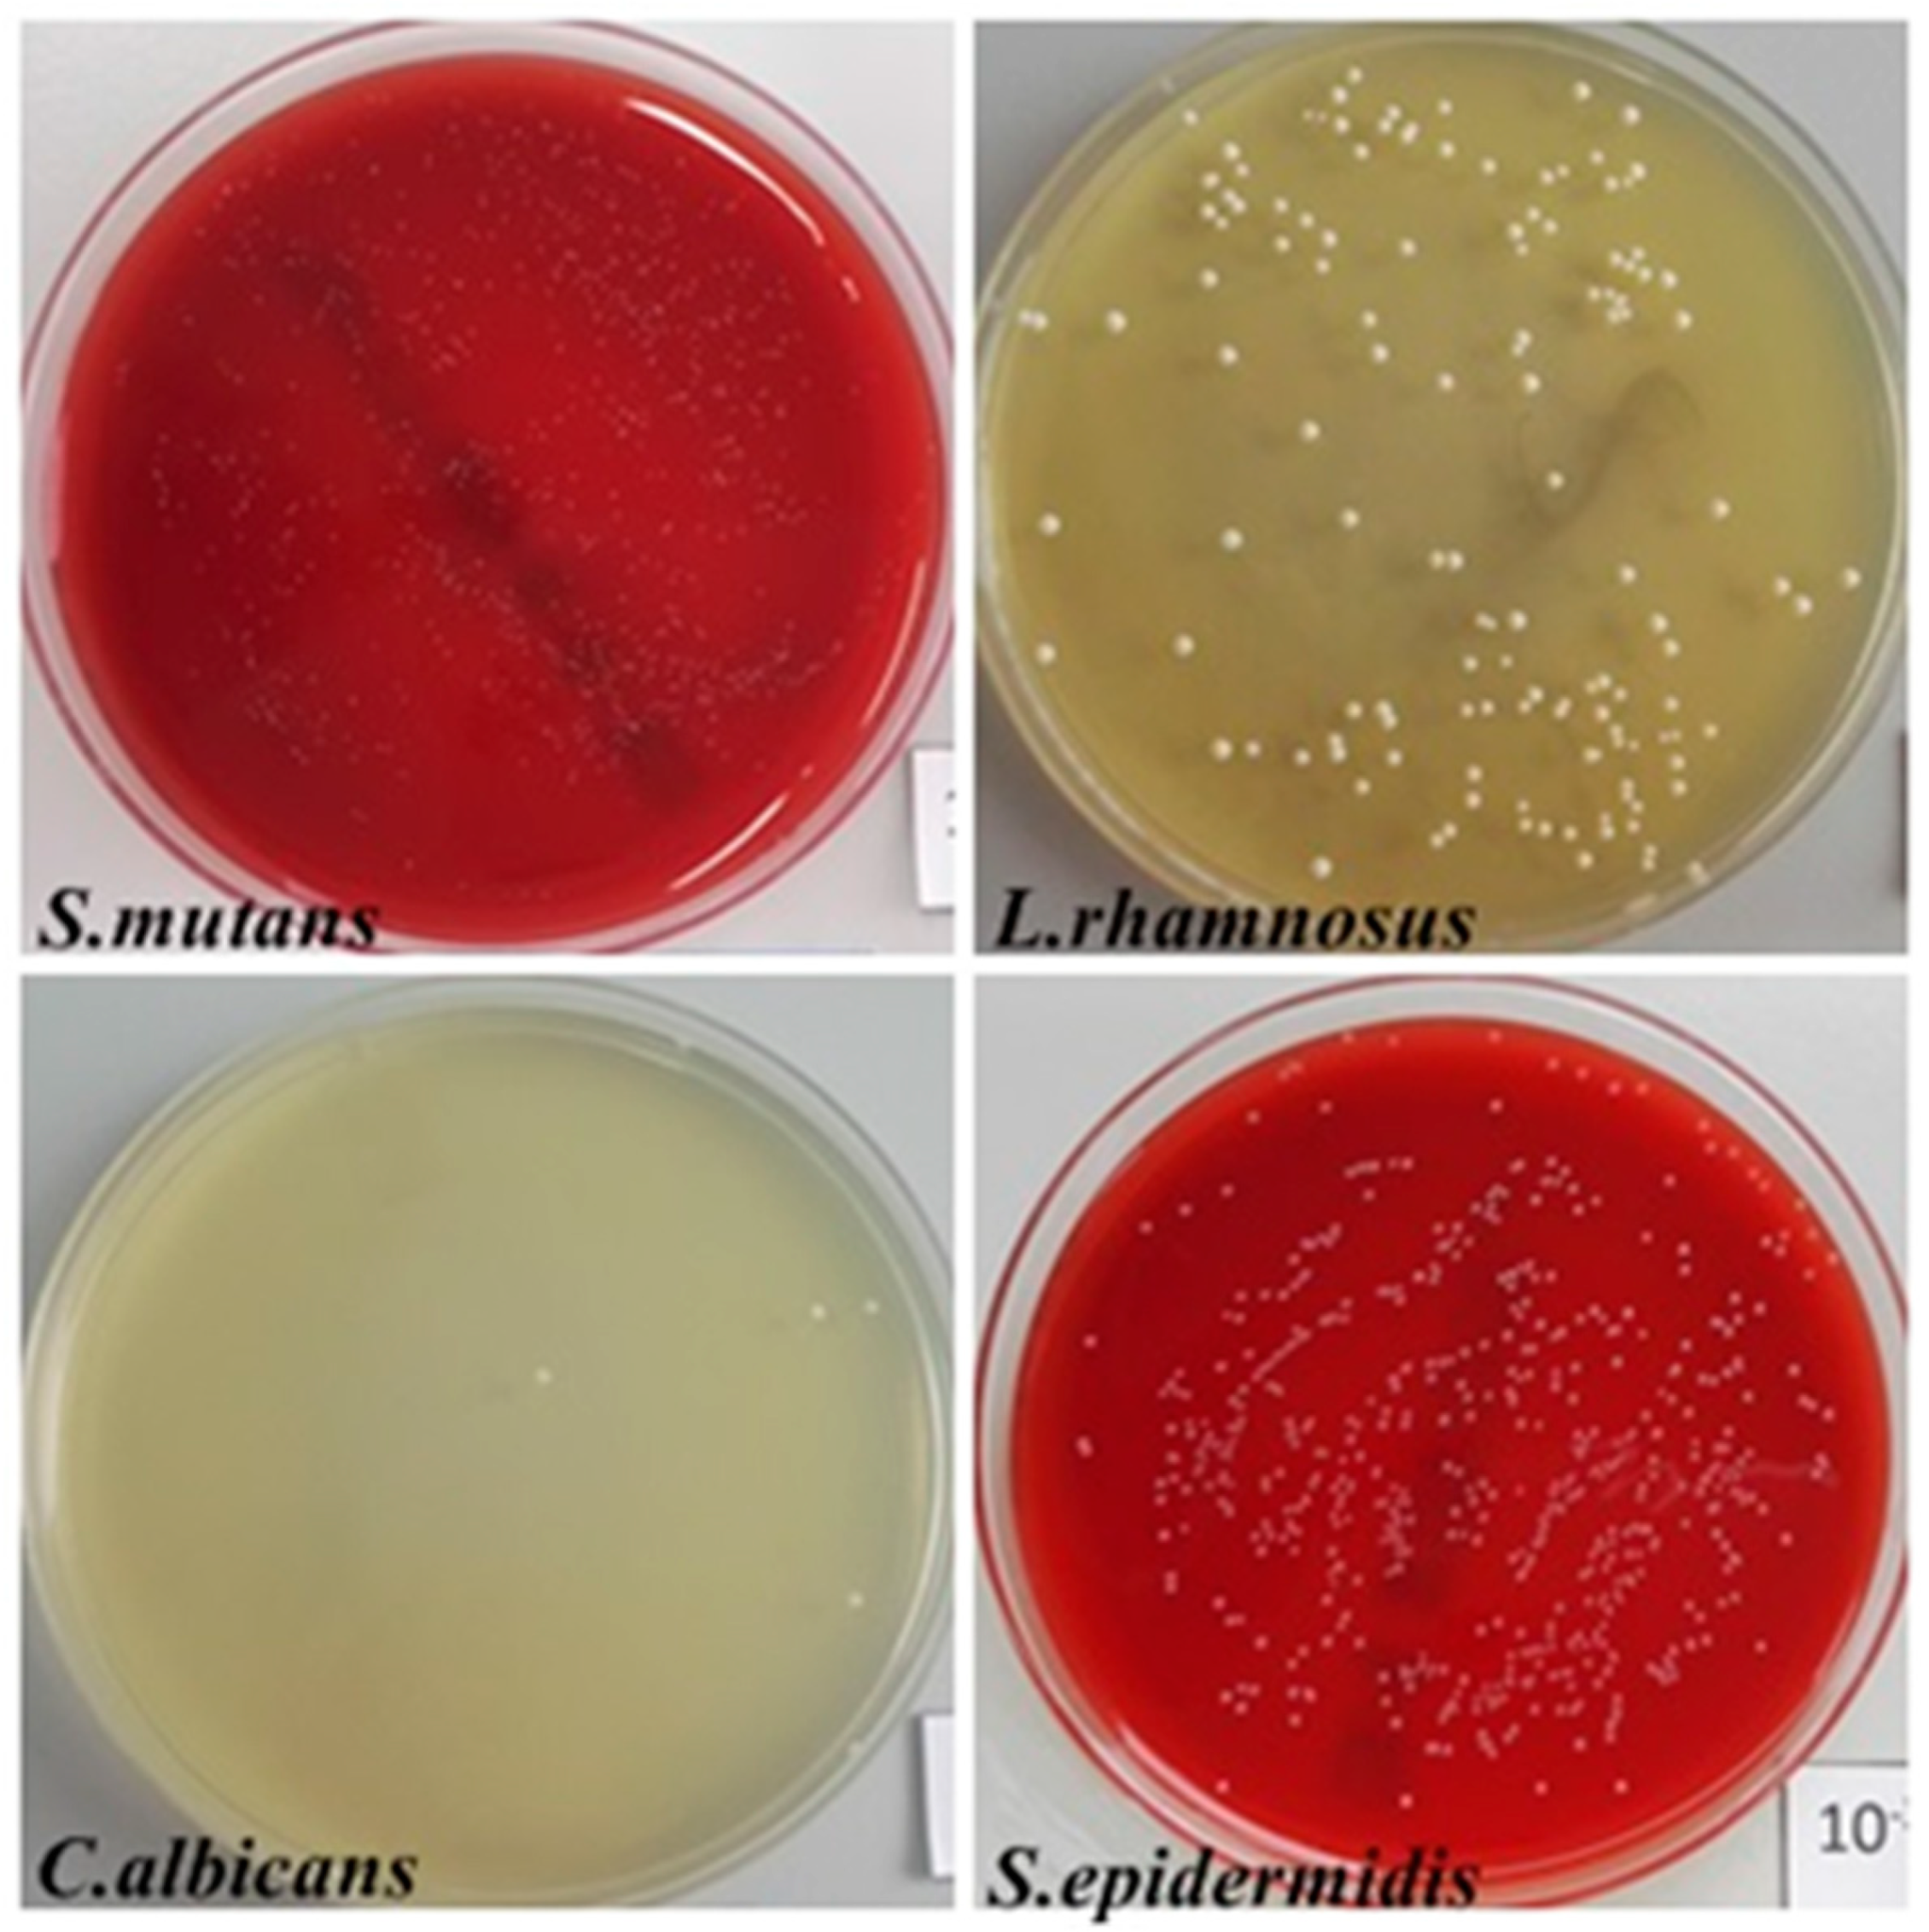
Biomedicines 12 01466 g006

Three-Dimensional-Printed Modular Titanium Alloy Plates for Osteosynthesis of the Jawbone
Abstract
1. Introduction
2. Materials and Methods
2.1. Titanium Modular Plates
2.2. Analysis of Titanium Modular Plate Composition
2.3. Analysis of the Structure and Topography
2.4. Analysis of the Contact Angle
2.5. Evaluation of the Roughness
2.6. Cell Culture
2.6.1. Direct Contact
2.6.2. Evaluation of Cell Morphology
2.6.3. Preparation of Extracts
2.6.4. MTT Assay
2.6.5. Cell Adhesion
2.7. Quantitative Evaluation of Bacterial Adhesion
2.8. Qualitative Assessment of Bacterial Biofilm Formation
2.9. Scanning Electron Microscopy (SEM)
2.10. Statistical Analysis
3. Results
3.1. Modular Titanium Plates Showed Hydrophobic Surface Properties
3.2. Modular Titanium Plates Showed No Cytotoxic Effects on Fibroblast Cells
3.3. Cell Adhesion on the Surface of the Plates
3.4. Adhesion and Microbial Biofilm Formation Were Selectively Reduced
3.5. Scanning Electron Microscopy (SEM) Revealed Differences in Biofilm Formation
4. Discussion
Author Contributions
Funding
Institutional Review Board Statement
Informed Consent Statement
Data Availability Statement
Acknowledgments
Conflicts of Interest
References
- Smith, K.E.; Dupont, K.M.; Safranski, D.L.; Blair, J.; Buratti, D.; Zeetser, V.; Callahan, R.; Lin, J.; Gall, K. Use of 3D printed bone plate in novel technique to surgically correct hallux valgus deformities. Tech. Orthop. 2016, 31, 181–189. [Google Scholar] [CrossRef]
- Tan, X.P.; Tan, Y.J.; Chow, C.S.L.; Tor, S.B.; Yeong, W.Y. Metallic powder-bed based 3D printing of cellular scaffolds for orthopaedic implants: A state-of-the-art review on manufacturing, topological design, mechanical properties and biocompatibility. Mater. Sci. Eng. C 2017, 76, 1328–1343. [Google Scholar] [CrossRef] [PubMed]
- Murr, L.E.; Esquivel, E.V.; Quinones, S.A.; Gaytan, S.M.; Lopez, M.I.; Martinez, E.Y.; Medina, F.; Hernandez, D.H.; Martinez, E.; Martinez, J.L.; et al. Microstructures and mechanical properties of electron beam-rapid manufactured Ti–6Al–4V biomedical prototypes compared to wrought Ti–6Al–4V. Mater. Charact. 2009, 60, 96–105. [Google Scholar] [CrossRef]
- Hollander, D.A.; von Walter, M.; Wirtz, T.; Richard Sellei, R.; Schmidt-Rohlfing, B.; Paar, O.; Erli, H.-J. Structural, mechanical and in vitro characterization of individually structured Ti–6Al–4V produced by direct laser forming. Biomaterials 2006, 27, 955–963. [Google Scholar] [CrossRef]
- Nicholson, J.W. Titanium Alloys for Dental Implants: A Review. Prosthesis 2020, 2, 100–116. [Google Scholar] [CrossRef]
- Xie, K.; Guo, Y.; Zhao, S.; Wang, L.; Wu, J.; Tan, J.; Yang, Y.; Wu, W.; Jiang, W.; Hao, Y. Partially Melted Ti6Al4V Particles Increase Bacterial Adhesion and Inhibit Osteogenic Activity on 3D-printed Implants: An in Vitro Study. Clin. Orthop. Relat. Res. 2019, 477, 2772–2782. [Google Scholar] [CrossRef] [PubMed]
- Gronkiewicz, K.; Majewski, P.; Wisniewska, G.; Pihut, M.; Loster, B.W.; Majewski, S. Experimental research on the possibilities of maintaining thermal conditions within the limits of the physiological conditions during intraoral preparation of dental implants. J. Physiol. Pharmacol. 2009, 60, 123–127. [Google Scholar] [PubMed]
- Makuch, K.; Koczorowski, R. Biokompatybilność tytanu oraz jego stopów wykorzystywanych w stomatologii Biocompatibility of Titanium and Its Alloys Used in Dentistry. Dent. Med. Probl. 2010, 47, 81–88. [Google Scholar]
- Sidambe, A.T. Biocompatibility of advanced manufactured titanium implants—A review. Materials 2014, 7, 8168–8188. [Google Scholar] [CrossRef]
- Yount, N.Y.; Yeaman, M.R. Multidimensional signatures in antimicrobial peptides. Proc. Natl. Acad. Sci. USA 2004, 101, 7363–7368. [Google Scholar] [CrossRef]
- Mosmann, T. Rapid colorimetric assay for cellular growth and survival: Application to proliferation and cytotoxicity assays. J. Immunol. Methods 1983, 65, 55–63. [Google Scholar] [CrossRef] [PubMed]
- DIN EN ISO 11562:1996; Geometrical Product Specifications (GPS)—Surface Texture: Profile Method—Metrological Characteristics of Phase Correct Filters. International Organization for Standardization (ISO): Geneva, Switzerland, 1996.
- Szymonowicz, M.; Rybak, Z.; Fraczek-Szczypta, A.; Paluch, D.; Rusak, A.; Nowicka, K.; Blazewicz, M. Haemocompatibility and cytotoxic studies of non-metallic composite materials modified with magnetic nano and microparticles. Acta Bioeng. Biomech. 2015, 17, 49–58. [Google Scholar] [CrossRef]
- Szymonowicz, M.; Rusak, A.; Pajączkowska, M.; Nowicka, J.; Wiśniewska, K.; Żywicka, B.; Rybak, Z.; Dobrzyński, M. Assessment of cytotoxic and antimicrobial activity of selected gingival haemostatic agents—In vitro study. Acta Bioeng. Biomech. 2020, 22, 185–198. [Google Scholar] [CrossRef] [PubMed]
- Żak, M.; Rusak, A.; Kuropka, P.; Szymonowicz, M.; Pezowicz, C. Mechanical properties and osteointegration of the mesh structure of a lumbar fusion cage made by 3D printing. J. Mech. Behav. Biomed. Mater. 2023, 141, 105762. [Google Scholar] [CrossRef] [PubMed]
- ISO 10993-5:2009; Biological Evaluation of Medical Devices—Part 5: Tests for In Vitro Cytotoxicity. International Organization for Standardization (ISO): Geneva, Switzerland, 2009.
- Tomanik, M.; Kobielarz, M.; Filipiak, J.; Szymonowicz, M.; Rusak, A.; Mroczkowska, K.; Antończak, A.; Pezowicz, C. Laser texturing as a way of influencing the micromechanical and biological properties of the poly(L-lactide) surface. Materials 2020, 13, 3786. [Google Scholar] [CrossRef]
- Sztyler, K.; Pajączkowska, M.; Nowicka, J.; Rusak, A.; Chodaczek, G.; Nikodem, A.; Wiglusz, R.J.; Watras, A.; Dobrzyński, M. Evaluation of the microbial, cytotoxic and physico-chemical properties of the stainless steel crowns used in pediatric dentistry. Acta Bioeng. Biomech. 2022, 24, 127–137. [Google Scholar] [CrossRef] [PubMed]
- ISO 10993:12; Biological Evaluation of Medical Devices—Part 12: Sample Preparation and Reference Materials. International Organization for Standardization (ISO): Geneva, Switzerland, 2012.
- ISO 25178:15; Geometrical Product Specifications (GPS)—Surface Texture: Areal—Part 1: Indication of Surface Texture. International Organization for Standardization (ISO): Geneva, Switzerland, 2015.
- Coelho, P.G.; Jimbo, R. Osseointegration of metallic devices: Current trends based on implant hardware design. Arch. Biochem. Biophys. 2014, 561, 99–108. [Google Scholar] [CrossRef] [PubMed]
- Morotomi, T.; Iuchi, T.; Hirano, N.; Fujita, M.; Niwa, K. Usefulness of Customized Titanium Plates for Midface Contouring Surgery. Int. J. Surg. Case Rep. 2022, 96, 107324. [Google Scholar] [CrossRef]
- Xue, R.; Lai, Q.; Xing, H.; Zhong, C.; Zhao, Y.; Zhu, K.; Deng, Y.; Liu, C. Finite Element Analysis and Clinical Application of 3D-Printed Ti Alloy Implant for the Reconstruction of Mandibular Defects. BMC Oral Health 2024, 24, 95. [Google Scholar] [CrossRef]
- Mazzoni, S.; Bianchi, A.; Schiariti, G.; Badiali, G.; Marchetti, C. Computer-Aided Design and Computer-Aided Manufacturing Cutting Guides and Customized Titanium Plates Are Useful in Upper Maxilla Waferless Repositioning. J. Oral Maxillofac. Surg. 2014, 73, 4. [Google Scholar] [CrossRef]
- Gauthier, M.; Menini, R.; Bureau, M.N.; So, S.K.V.; Dion, M.-J.; Lefebvre, L.P. Properties of Novel Titanium Foams Intended for Biomedical Applications. In Proceedings of the ASM Materials & Processes for Medical Devices Conference, Anaheim, CA, USA, 8–10 September 2003; pp. 382–387. [Google Scholar]
- Petersen, R.C. Titanium Implant Osseointegration Problems with Alternate Solutions Using Epoxy/Carbon-Fiber-Reinforced Composite. Metals 2014, 4, 549–569. [Google Scholar] [CrossRef] [PubMed]
- Krzyściak, W.; Jurczak, A.; Kościelniak, D.; Bystrowska, B.; Skalniak, A. The virulence of Streptococcus mutans and the ability to form biofilms. Eur. J. Clin. Microbiol. Infect. Dis. 2014, 33, 499–515. [Google Scholar] [CrossRef] [PubMed]
- Song, Y.G.; Lee, S.H. Inhibitory effects of Lactobacillus rhamnosus and Lactobacillus casei on Candida biofilm of denture surface. Arch. Oral Biol. 2017, 76, 1–6. [Google Scholar] [CrossRef] [PubMed]
- Sabaté Brescó, M.; Harris, L.G.; Thompson, K.; Stanic, B.; Morgenstern, M.; O’Mahony, L.; Richards, R.G.; Moriarty, T.F. Pathogenic mechanisms and host interactions in Staphylococcus epidermidis device-related infection. Front. Microbiol. 2017, 8, 01401. [Google Scholar] [CrossRef] [PubMed]
- Nowicka, J.; Janczura, A.; Pajączkowska, M.; Chodaczek, G.; Szymczyk-Ziółkowska, P.; Walczuk, U.; Gościniak, G. Effect of Camel Peptide on the Biofilm of Staphylococcus epidermidis and Staphylococcus haemolyticus Formed on Orthopedic Implants. Antibiotics 2023, 12, 1671. [Google Scholar] [CrossRef] [PubMed]
- Oda, Y.; Miura, T.; Mori, G.; Hodaka Sasaki, H.; Ito, T.; Yoshinari, M.; Yajima, Y. Adhesion of streptococci to titanium and zirconia. PLoS ONE 2020, 15, 0234524. [Google Scholar] [CrossRef] [PubMed]
- Lassila, L.V.J.; Garoushi, S.; Tanner, J.; Vallittu, P.K.; Söderling, E. Adherence of Streptococcus mutans to Fiber-Reinforced Filling Composite and Conventional Restorative Materials. Open Dent. J. 2009, 3, 227–232. [Google Scholar] [CrossRef]
- Bahije, L.; Benyahia, H.; El Hamzaoui, S.; Ebn Touhami, M.; Bengueddour, R.; Rerhrhaye, W.; Abdallaoui, F.; Zaoui, F. Behavior of NiTi in the presence of oral bacteria: Corrosion by Streptococcus mutans. Int. Orthod. 2011, 9, 110–119. [Google Scholar] [CrossRef] [PubMed]
- Meza-Siccha, A.S.; Aguilar-Luis, M.A.; Silva-Caso, W.; Mazulis, F.; Barragan-Salazar, C.; del Valle-Mendoza, J. In vitro evaluation of bacterial adhesion and bacterial viability of Streptococcus mutans, Streptococcus sanguinis, and Porphyromonas gingivalis on the abutment surface of titanium and zirconium dental implants. Int. J. Dent. 2019, 2019, 4292976. [Google Scholar] [CrossRef] [PubMed]
- Metwalli, K.H.; Khan, S.A.; Krom, B.P.; Jabra-Rizk, M.A. Streptococcus mutans, Candida albicans, and the Human Mouth: A Sticky Situation. PLoS Pathog. 2013, 9, 1003616. [Google Scholar] [CrossRef]
- Kucharíková, S.; Gerits, E.; De Brucker, K.; Braem, A.; Ceh, K.; Majdič, G.; Španič, T.; Pogorevc, E.; Verstraeten, N.; Tournu, H.; et al. Covalent immobilization of antimicrobial agents on titanium prevents Staphylococcus aureus and Candida albicans colonization and biofilm formation. J. Antimicrob. Chemother. 2016, 71, 936–945. [Google Scholar] [CrossRef] [PubMed]
- Mouhat, M.; Moorehead, R.; Murdoch, C. In vitro Candida albicans biofilm formation on different titanium surface topographies. Biomater. Investig. Dent. 2020, 7, 146–157. [Google Scholar] [CrossRef] [PubMed]
- Ciandrini, E.; Campana, R.; Baffone, W. Live and heat-killed Lactobacillus spp. interfere with Streptococcus mutans and Streptococcus oralis during biofilm development on titanium surface. Arch. Oral Biol. 2017, 78, 48–57. [Google Scholar] [CrossRef] [PubMed]
- Neoh, K.G.; Hu, X.; Zheng, D.; Kang, E.T. Balancing osteoblast functions and bacterial adhesion on functionalized titanium surfaces. Biomaterials 2012, 33, 2813–2822. [Google Scholar] [CrossRef] [PubMed]

| Textural Structure Parameters | Surface Topography | Surface Roughness | Surface Waviness |
|---|---|---|---|
| Sa [µm] | 12.587 ± 1.731 | 2.757 ± 0.863 | 11.047 ± 1.037 |
| Sq [µm] | 16.534 ± 1.947 | 4.542 ± 1.298 | 14.410 ± 1.244 |
| Sz [µm] | 132.836 ± 17.585 | 93.320 ± 30.105 | 88.581 ± 7.371 |
| Ssk [-] | −0.936 ± 0.292 | −1.560 ± 1.74 | −0.841 ± 0.186 |
| Sku [-] | 4.506 ± 0.796 | 17.908 ± 3.104 | 4.135 ± 0.173 |
| Sp [µm] | 53.920 ± 25.915 | 46.732 ± 31.245 | 30.604 ± 3.131 |
| Sv [µm] | 78.916 ± 8.33 | 46.587 ± 1.139 | 57.977 ± 4.241 |
| Species | S. mutans M ± SD | L. rhamnosus M ± SD | C. albicans M ± SD | S. epidermidis M ± SD |
|---|---|---|---|---|
| CFU/mL | 6.38 × 106 ± 2.30 × 10⁵ | 1.3 × 106 ± 1.20 × 10⁵ | 6.0 × 104 ± 2.0 × 103 | 1.07 × 106 ± 7.55 × 10⁴ |
Disclaimer/Publisher’s Note: The statements, opinions and data contained in all publications are solely those of the individual author(s) and contributor(s) and not of MDPI and/or the editor(s). MDPI and/or the editor(s) disclaim responsibility for any injury to people or property resulting from any ideas, methods, instructions or products referred to in the content. |
© 2024 by the authors. Licensee MDPI, Basel, Switzerland. This article is an open access article distributed under the terms and conditions of the Creative Commons Attribution (CC BY) license (https://creativecommons.org/licenses/by/4.0/).
Share and Cite
Dobrzyński, M.; Szymonowicz, M.; Nowicka, J.; Pajączkowska, M.; Nikodem, A.; Kuropka, P.; Wawrzyńska, M.; Rusak, A. Three-Dimensional-Printed Modular Titanium Alloy Plates for Osteosynthesis of the Jawbone. Biomedicines 2024, 12, 1466. https://doi.org/10.3390/biomedicines12071466
Dobrzyński M, Szymonowicz M, Nowicka J, Pajączkowska M, Nikodem A, Kuropka P, Wawrzyńska M, Rusak A. Three-Dimensional-Printed Modular Titanium Alloy Plates for Osteosynthesis of the Jawbone. Biomedicines. 2024; 12(7):1466. https://doi.org/10.3390/biomedicines12071466
Chicago/Turabian StyleDobrzyński, Maciej, Maria Szymonowicz, Joanna Nowicka, Magdalena Pajączkowska, Anna Nikodem, Piotr Kuropka, Magdalena Wawrzyńska, and Agnieszka Rusak. 2024. "Three-Dimensional-Printed Modular Titanium Alloy Plates for Osteosynthesis of the Jawbone" Biomedicines 12, no. 7: 1466. https://doi.org/10.3390/biomedicines12071466
APA StyleDobrzyński, M., Szymonowicz, M., Nowicka, J., Pajączkowska, M., Nikodem, A., Kuropka, P., Wawrzyńska, M., & Rusak, A. (2024). Three-Dimensional-Printed Modular Titanium Alloy Plates for Osteosynthesis of the Jawbone. Biomedicines, 12(7), 1466. https://doi.org/10.3390/biomedicines12071466

